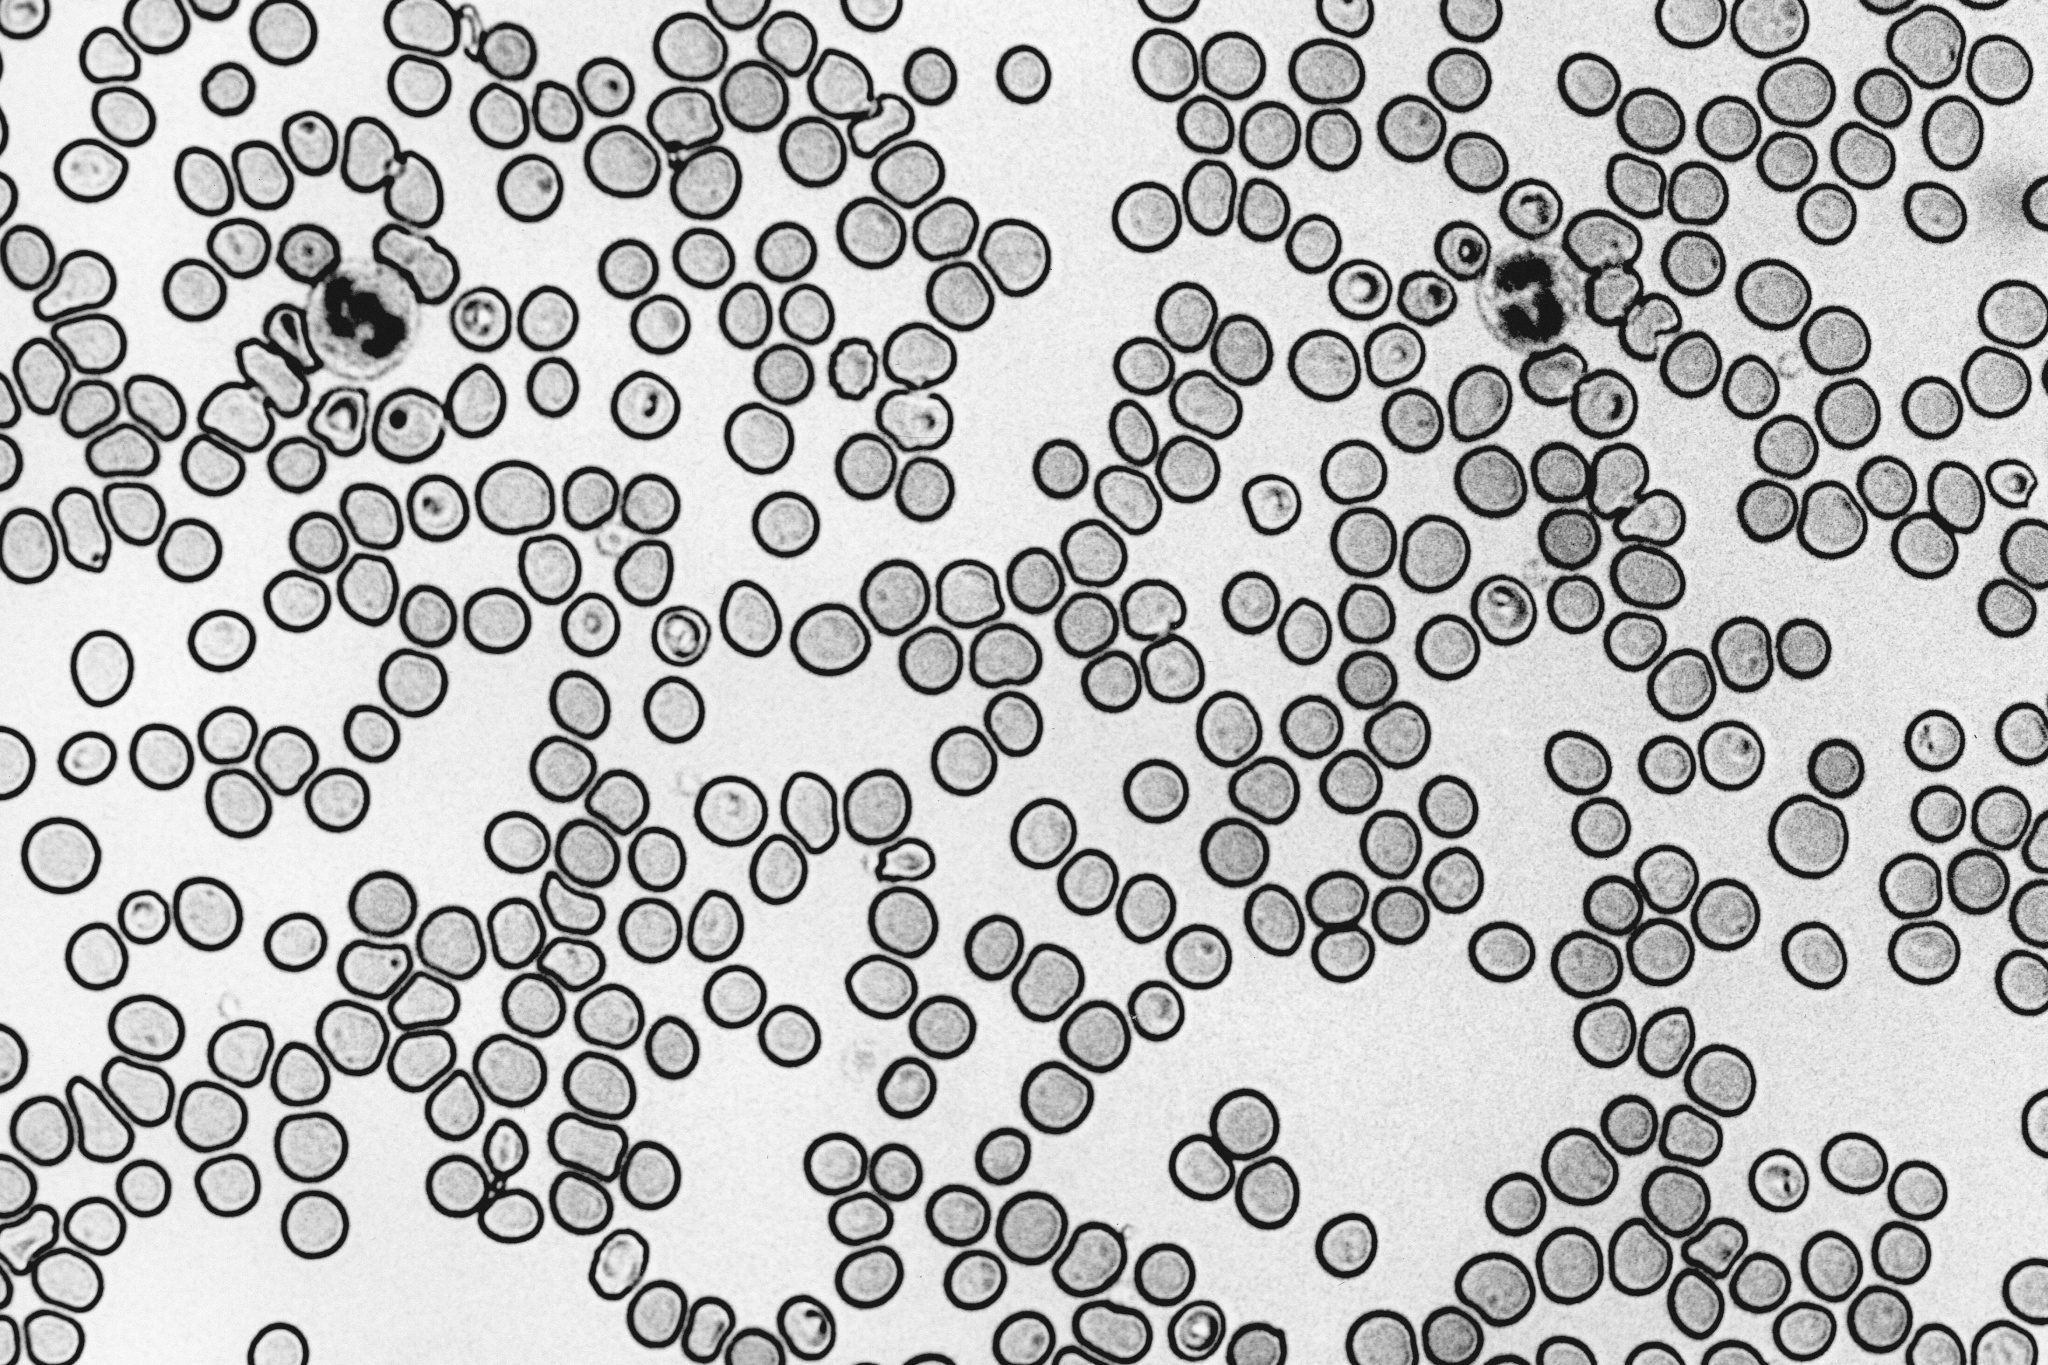
c6e63d7fa1f0c43f94af23378afd73d4_ce_4392x2928x0x1365.jpg

Стесняюсь спросить: как гормоны и метаболизм влияют на энергию?
Если вы постоянно чувствуете усталость, «разбитость» с утра, туман в голове и вам все сложнее концентрироваться, не спешите списывать это на стресс или недосып. Часто корень этой проблемы глубже — в области нарушенного обмена веществ и гормонального дисбаланса. Давайте разберемся, как инсулинорезистентность незаметно крадет вашу энергию и что с этим делать.
Что такое инсулинорезистентность?
Представьте, что каждая клетка вашего тела — это дом, которому для работы нужна энергия (глюкоза). А инсулин как ключ, который открывает двери клеток, чтобы впустить глюкозу внутрь.
Состояние, когда ваши клетки перестают узнавать ключ, и будет проявлением инсулинорезистентности. Они сопротивляются инсулину, и их двери не открываются. В ответ поджелудочная железа начинает производить еще больше ключей (инсулина), чтобы преодолеть это сопротивление.
В результате в крови циркулирует много и глюкозы, и инсулина, но сами клетки голодают и не получают топлива. Это состояние — это как умирать от голода перед полным холодильником, который вы не можете открыть.
При чем здесь усталость?
Инсулинорезистентность запускает механизм хронической усталости через следующие моменты.
1. Энергетический голод на клеточном уровне
Ваши мышцы и мозг — главные потребители энергии. Когда инсулин не может доставить глюкозу в мышечные клетки, вы чувствуете физическую слабость. Когда же нейроны мозга недополучают топливо, появляются «туман в голове», проблемы с памятью и концентрацией. Просыпаясь, вы уже чувствуете себя уставшим, потому что ваше тело не восстановило энергию за ночь.
